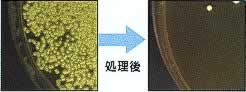

|
|
■包装資材 ■包装機械 ■物流機器 ■測定機器 ■洗剤 ■ケミカル ■蛍光灯 ■季節品-夏 ■季節品-冬 ■弱電工具 ■ホイスト ■環境機器 ■掃除機 ■ムーブテック ■切削工具 ■機械工具■調理厨房機器 ■研究室用品 ■安全防犯防災品 ■エクステリア ■新商品 ■在庫処分
| 衣服用(白衣)オゾン殺菌庫/品番 M812SB-W08K | 【詳細表示】 | ||||||||||||||||||||||||||||||||||||||||||||||||
| 商品番号 | M812SB-W08K | 価 格 | |||||||||||||||||||||||||||||||||||||||||||||||
 |
オゾンの力で白衣や作業着を隅々まで確実に殺菌・脱臭 オゾンの持つ強い殺菌・脱臭力で白衣、作業着、帽子、上履きなどを清潔に保ちます。 各種機構により高い安全性を確保しています。 |
衣服用(白衣)オゾン殺菌庫 品番 M812SB-W08K 価格は下記をご覧下さい |
|||||||||||||||||||||||||||||||||||||||||||||||
| ■特長 ●白衣の隅々まで殺菌 オゾンは気体のため繊維の隅々まで行き渡ります。 ●ステンレス材による密閉構造 オゾンによる庫内の劣化および、庫外への漏れの心配がありません。 ●各種安全機構 運転中の扉ロック・オゾン漏れ検知センサー・排オゾン分解触媒を装備しています。  ■使用方法 扉を開けて白衣などを入れる ↓ スタートボタンを押す ↓ オゾン処理開始 (M812SB-W08K:75分/M812SB-WS8K:105分) ↓ オゾン分解(15分) ↓ 扉を開けて白衣などを取り出す ■各部名称  ■紫外線とオゾン殺菌の違い  ■殺菌試験 試験機関:(株)信濃公害研究所 <黄色ブドウ球菌> 1回のオゾン処理で99.2%の細菌が死滅 ■タイプ
■仕様
|
|||||||||||||||||||||||||||||||||||||||||||||||||
運賃、および消費税は、記載価格には、含まれていません。

[トップページに戻る] [注文書] [見積り依頼] TEL 0729-64-8663 FAX 0729-61-4874
営業時間 AM9:00~PM7:00 営業日 月曜日~金曜日 定休日 土曜日 日曜日 祝日